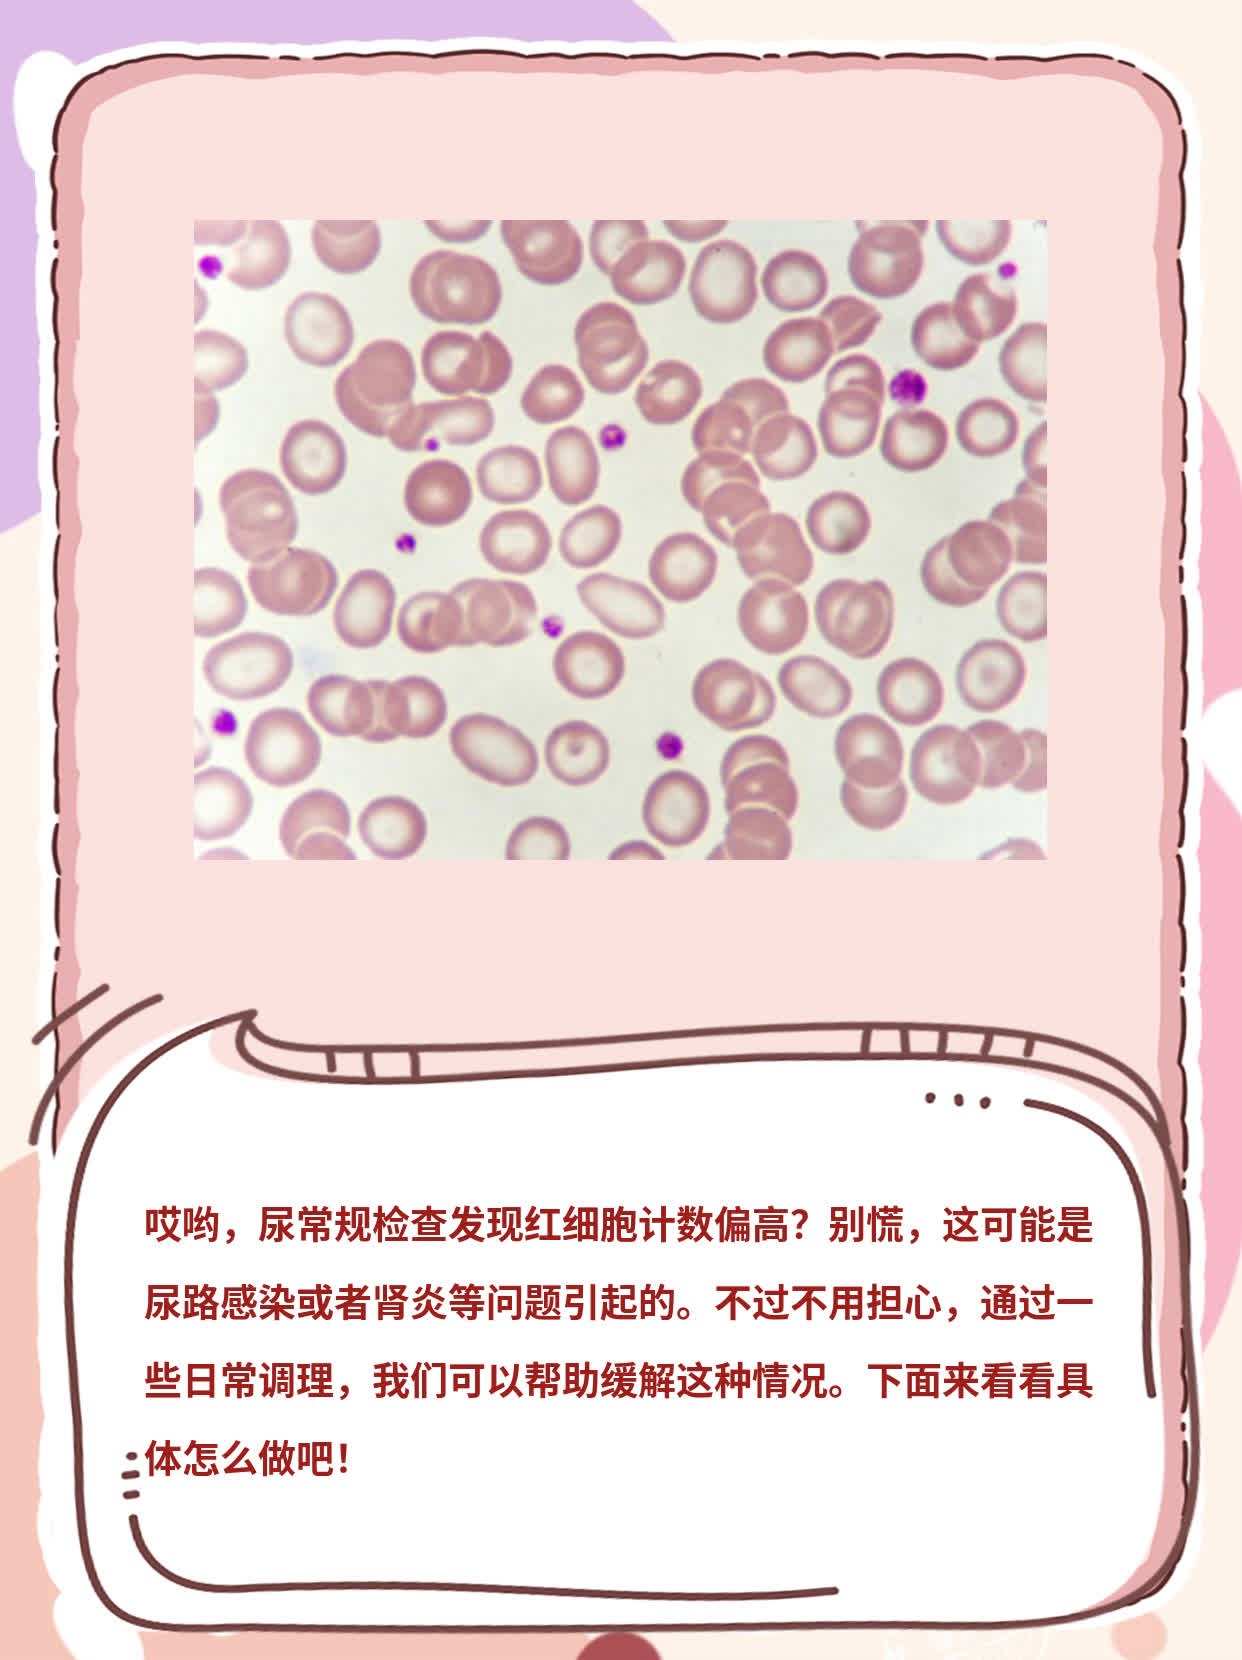
尿检红细胞异常分析

4 生理性因素剧烈运动后,肾脏血流重新分配可能导致肾小球滤过膜暂时性通透性增加,引发“运动性血尿”,通常休息后可缓解此外,感染如上呼吸道感染肾下垂肾脏位置异常或胡桃夹综合征左肾静脉受压也可能通过机械性压迫或血流动力学改变导致血尿注意事项与建议尿检红细胞高并非一定提示严重;尿检中异常红细胞特别多,通常提示可能患有肾炎具体来说血尿原因分类尿中出现红细胞,即血尿,主要分为两大类原因第一类是肾炎性疾病,第二类是非肾炎性疾病非肾炎性疾病这类原因以肾结石尿路感染肾脏肿瘤等为代表这些原因引起的血尿,多数是泌尿道损伤所致,红细胞不出现变形,异常红细胞比例较低肾炎性疾病;尿液分析明确红细胞数量形态及是否伴蛋白尿白细胞泌尿系统超声筛查结石肿瘤或结构异常肾功能检查评估肾脏滤过与排泄功能进一步检查如CTMRI或红细胞形态分析,辅助诊断病因治疗原则病因不同,治疗方案各异感染使用抗生素控制炎症结石根据大小选择药物排石体外碎石或手术取石;3肿瘤相关症状无痛性血尿体重下降贫血或腹部肿块4肾小球疾病症状蛋白尿水肿高血压,可能伴肾功能异常5其他情况胡桃夹现象多见于青少年,剧烈运动后血尿通常短暂,药物副作用需结合用药史判断三诊断方法1尿液检查复查红细胞形态变形红细胞提示肾小球源性,正常形态提示非肾;尿检红细胞高通常提示尿液中存在异常数量的红细胞,可能由以下原因引起1 泌尿系统感染尿路感染如膀胱炎肾盂肾炎是常见原因感染导致黏膜充血破损,红细胞渗入尿液,常伴随尿频尿急尿痛或发热等症状细菌直接损伤尿路黏膜,或炎症反应引发局部出血,均可导致红细胞增多2 泌尿系统结石肾结;一生理性影响因素1年龄与性别儿童剧烈运动后可能因肾脏微小血管暂时受损,出现尿液红细胞轻度增多,但休息后可恢复女性月经期经血混入尿液会导致检测结果异常升高,需避开经期留取标本2生活方式长期大量饮水会稀释尿液,使红细胞相对浓度降低长时间憋尿可能改变尿液细胞状态,导致检测偏差高温。
尿检红细胞45属于比较严重的情况具体分析如下红细胞数量超出正常范围正常尿液中红细胞数量极少,通常每高倍视野下不超过3个尿检红细胞45单位可能为μL或HP,需结合检测方法确认已显著高于正常值,提示尿液中红细胞含量明显异常这种数值变化往往与泌尿系统实质性病变相关,需引起重视多由泌尿;尿检中红细胞偏高的原因主要分为以下四类一肾脏疾病肾小球滤过膜受损是核心机制如肾小球肾炎急慢性,免疫反应导致滤过膜通透性增加,红细胞漏入尿液急性多见于儿童青少年,伴蛋白尿水肿高血压慢性起病隐匿,可发生于任何年龄肾盂肾炎由逆行感染引发,女性更易患病,除血尿外伴发热;5 肿瘤与结构异常泌尿系统肿瘤如肾癌膀胱癌可能因肿瘤表面坏死或侵犯血管导致持续血尿此外,前列腺增生老年人常见或泌尿系统先天畸形如多囊肾也可能引发红细胞尿注意事项尿检红细胞高不一定代表严重疾病,但需结合症状如尿频尿痛腰痛和病史综合判断及时就医是关键,医生可能;尿检红细胞542,白细胞26,不正常以下是具体的分析红细胞异常尿检中红细胞数为542,远超过正常范围红细胞增多可能表明尿液中存在血液,这可能是由结石炎症结核肿瘤等多种原因引起的泌尿系统损伤白细胞轻度升高尿检中白细胞数为26,虽然较正常值有所升高,但相较于红细胞数的异常,其;2泌尿系统结石结石是尿检红细胞升高的常见原因之一当结石直径较大或移动时,可能划伤尿路黏膜如肾盂输尿管或膀胱,引发机械性损伤和出血例如,肾结石在排出过程中可能刺激肾盂黏膜,导致镜下血尿或肉眼血尿患者常表现为腰部或腹部绞痛血尿及排尿不适,超声或CT可明确结石位置及大小3;4 肾小球疾病急性或慢性肾小球肾炎导致肾小球滤过膜损伤,红细胞漏出至尿液患者可能伴有水肿高血压或肾功能异常5 其他原因 生理性因素剧烈运动过度劳累或长时间站立可能导致暂时性血尿,休息后通常缓解药物副作用抗凝药如华法林化疗药等可能干扰凝血功能,引发血尿胡桃夹现象左肾。
全身性疾病也可能引发尿检红细胞异常心血管疾病如高血压心力衰竭会损害肾脏血管,导致红细胞漏出血液系统疾病如贫血血小板减少性紫癜因凝血功能障碍,易引发出血自身免疫性疾病如系统性红斑狼疮类风湿关节炎会通过免疫复合物沉积损伤肾脏,引发炎症反应其他原因包括剧烈运动后肾脏血管;在行尿常规检查的时候,发现异常红细胞特别多,提示是得了肾炎尿中出现红细胞,称之为血尿,原因分成两大类,第一类,是肾炎性疾病,第二类,是非肾炎性疾病非肾炎性疾病,以肾结石尿路感染肾脏方面的肿瘤为代表这些原因引起的血尿,多数是泌尿道损伤所引起的,所以红细胞是不出现变形的,异常;男性尿检红细胞高可能由多种原因引起,需结合具体症状和进一步检查明确病因以下是常见原因及应对措施1 泌尿系统感染尿道炎膀胱炎或肾盂肾炎等感染性疾病,会导致尿路黏膜充血水肿,红细胞渗出至尿液患者常伴尿频尿急尿痛或发热等症状抗感染治疗是主要手段,需通过细菌培养确定病原体后。
尿检中红细胞偏高可能由以下原因造成1 泌尿系统疾病肾小球肾炎肾盂肾炎膀胱炎尿道炎等炎症性疾病可导致肾小球滤过膜受损,使红细胞漏入尿液这类疾病通常伴随尿频尿急尿痛或腰痛等症状,需通过尿常规肾功能检查及影像学检查确诊2 泌尿系统结石结石在移动过程中可能划伤尿路黏膜,引发出;尿检红细胞计数高提示尿液中存在异常数量的红细胞,可能由以下原因导致1 泌尿系统疾病肾小球疾病如急性慢性肾小球肾炎会破坏肾小球滤过膜,导致红细胞漏出肾小管疾病如间质性肾炎可因肾小管损伤引发血尿泌尿系统结石肾结石输尿管结石会划伤尿路黏膜,造成红细胞渗出肿瘤如肾癌膀胱癌也可能直接引起血尿2;尿检结果中异形红细胞的出现,通常提示存在慢性肾炎以下是对此问题的详细解答异形红细胞的意义诊断肾炎的重要指标异形红细胞,即形态异常的红细胞,在尿检中的出现往往与肾脏疾病,尤其是慢性肾炎密切相关这些红细胞在通过受损的肾小球基底膜时,会受到挤压或变形,从而形成异形红细胞与均一红细胞。
转载请注明来自极限财经,本文标题:《尿检红细胞异常分析》

京公网安备11000000000001号
京公网安备11000000000001号 京ICP备11000001号
京ICP备11000001号
还没有评论,来说两句吧...